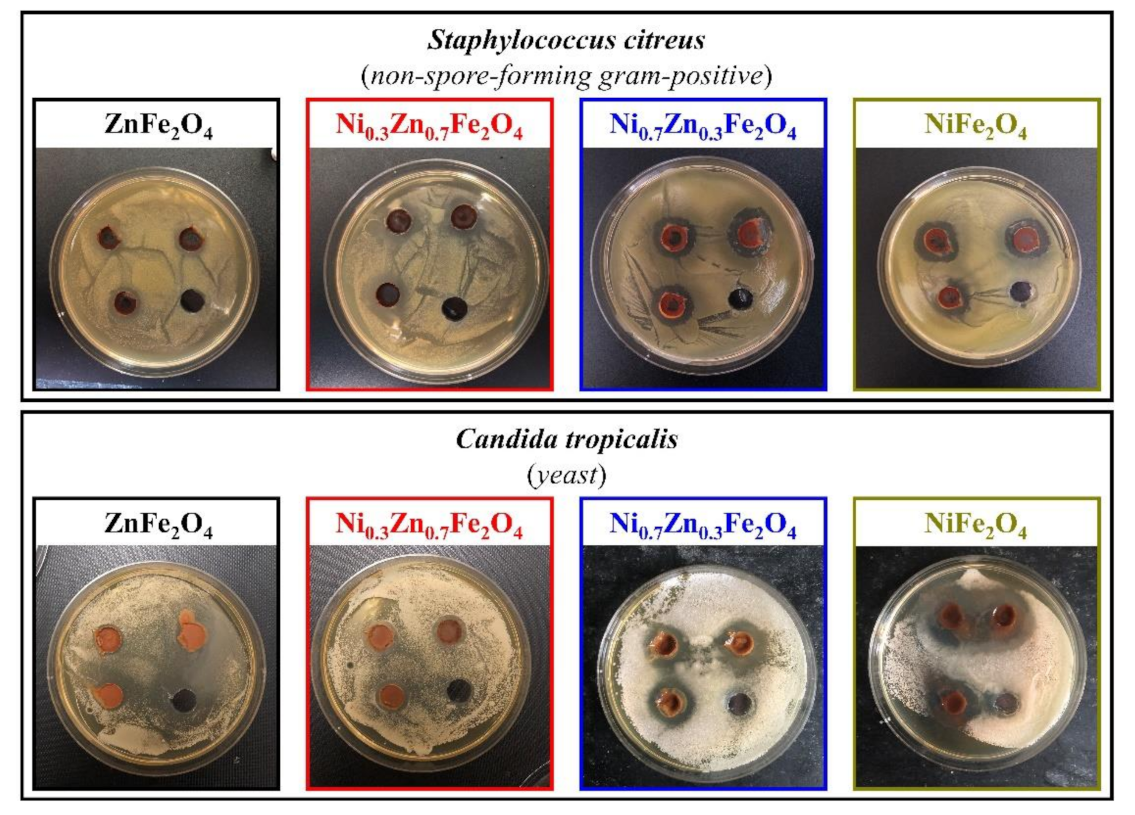
Water 14 00454 g007

Synthesis, Structure, and Antimicrobial Performance of NixZn1−xFe2O4 (x = 0, 0.3, 0.7, 1.0) Magnetic Powders toward E. coli, B. cereus, S. citreus, and C. tropicalis
Abstract
:1. Introduction
2. Materials and Methods
2.1. Materials
2.2. Synthesis of Initial Powder
2.3. Physicochemical Characterization
2.4. Antimicrobial Activity Test
2.4.1. Preparation of Bacterial and Yeast Cell Culture Media
2.4.2. Inhibition Zone Assay
2.4.3. Growth Curve Assay
2.4.4. MIC and MBC Assay
3. Results
3.1. Powder X-ray Diffraction and Elemental Characterization
3.2. FT-IR Spectroscopy
3.3. Low-Temperature N2 Sorption-Desorption Analysis
3.4. Morphology Analysis
3.5. Magnetic Properties
3.6. Inhibition Zone Assay
3.7. Growth Curve Assay
3.8. MIC and MBC Assay
4. Conclusions
Author Contributions
Funding
Institutional Review Board Statement
Informed Consent Statement
Data Availability Statement
Acknowledgments
Conflicts of Interest
References
- Ranga, R.; Kumar, A.; Kumari, P.; Singh, P.; Madaan, V.; Kumar, K. Ferrite application as an electrochemical sensor: A review. Mater. Charact. 2021, 178, 111269. [Google Scholar] [CrossRef]
- Abbas, N.; Rubab, N.; Sadiq, N.; Manzoor, S.; Khan, M.I.; Garcia, J.F.; Aragao, I.B.; Tariq, M.; Akhtar, Z.; Yasmin, G. Aluminum-doped cobalt ferrite as an efficient photocatalyst for the abatement of methylene blue. Water 2021, 12, 2285. [Google Scholar] [CrossRef]
- Thakur, P.; Taneja, S.; Chahar, D.; Ravelo, D.; Thakur, B. Recent advances on synthesis, characterization and high frequency applications of Ni-Zn ferrite nanoparticles. J. Magn. Magn. Mater. 2021, 530, 167925. [Google Scholar] [CrossRef]
- Kumar, E.R.; Jayaprakash, R.; Seehra, M.S.; Prakash, T.; Kumar, S. Effect of α-Fe2O3 phase on structural, magnetic and dielectric properties of Mn-Zn ferrite nanoparticles. J. Phys. Chem. Solids 2013, 74, 943–949. [Google Scholar] [CrossRef]
- Kumar, E.R.; Reddy, P.S.P.; Devi, G.S.; Sathiyaraj, S. Structural, dielectric and gas sensing behavior of Mn substituted spinel MFe2O4 (M = Zn, Cu, Ni, and Co) ferrite nanoparticles. J. Magn. Magn. Mater. 2016, 398, 281–288. [Google Scholar] [CrossRef]
- Ramadevi, P.; Kousi, F.; Sangeetha, A.; Gibson, M.S.M.; Shanmugavadivu, Ra. Structural and electrochemical investigation on pure and nickel doped cobalt ferrite nanoparticles for supercapacitor application. Mater. Today Proc. 2020, 33, 2238–2243. [Google Scholar] [CrossRef]
- Martinson, K.D.; Kozyritskaya, S.S.; Panteleev, I.B.; Popkov, V.I. Low coercivity ceramics based on LiZnMn ferrite synthesized via glycine-nitrate combustion. Nanosyst. Phys. Chem. Math. 2019, 10, 313–317. [Google Scholar] [CrossRef] [Green Version]
- Wang, J.; He, Z.; Wang, Y.; Lu, M. Electrochemical/Peroxymonosulfate/NrGO-MnFe2O4 for advanced treatment of landfill leachate nanofiltration concentrate. Water 2021, 13, 413. [Google Scholar] [CrossRef]
- Deepty, M.; Srinivas, Ch.; Kumar, E.R.; Mohan, N.K.; Prajapat, C.L.; Rao, T.V.C.; Meena, S.S.; Verma, A.K.; Sastry, D.L. XRD, EDX, FTIR and ESR spectroscopic studies of co-precipitated Mn-substituted Zn-ferrite nanoparticles. Ceram. Int. 2019, 45, 8037–8044. [Google Scholar] [CrossRef]
- Sorescu, M.; Diamandescu, L.; Peelamedu, R.; Roy, R.; Yadoji, P. Structural and magnetic properties of NiZn ferrites prepared by microwave sintering. J. Magn. Magn. Mater. 2004, 279, 195–201. [Google Scholar] [CrossRef]
- Yoo, J.-E.; Kang, Y.-M. Electromagnetic wave absorbing properties of Ni-Zn ferrite powder-epoxy composites in GHz range. J. Magn. Magn. Mater. 2020, 513, 167075. [Google Scholar] [CrossRef]
- Martinson, K.D.; Ivanov, A.A.; Panteleev, I.B.; Popkov, V.I. Effect of sintering temperature on the synthesis of LiZnMnFe microwave ceramics with controllable electro/magnetic properties. Ceram. Int. 2021, 47, 30071–30081. [Google Scholar] [CrossRef]
- Borade, R.M.; Kale, S.B.; Tekale, S.U.; Jadhav, K.M.; Pawar, R.P. Cobalt ferrite magnetic nanoparticles as highly efficient catalyst for the mechanochemical synthesis of 2-aey; benzimidazoles. Catal. Commun. 2021, 159, 106349. [Google Scholar] [CrossRef]
- El-Hafiz, D.R.A.; Sakr, A.A.-E.; Ebiad, M.A. Methane Bi-reforming for direct ethanol production over smart Cu/Mn-ferrite catalyst. Renew. Energy 2021, 167, 236–247. [Google Scholar] [CrossRef]
- Sonu; Sharma, S.; Dutta, V.; Raizada, P.; Hosseini-Bandegharaei, A.; Thakur, V.; Nguyen, V.-H.; VanLe, Q.; Singh, P. An overview of heterojunctioned ZnFe2O4 photocatalyst for enhanced oxidative water purification. J. Environ. Chem. Eng. 2021, 9, 105812. [Google Scholar] [CrossRef]
- Park, C.M.; Kim, Y.M.; Kim, K.-H.; Wang, D.; Su, C.; Yoon, Y. Potential utility of graphene-based nano spinel ferrites as adsorbent and photocatalyst for removing organic/inorganic contaminants from aqueous solutions: A mini-review. Chemosphere. 2019, 221, 392–402. [Google Scholar] [CrossRef]
- Singh, S.; Singhal, S. Transition metal-doped cobalt ferrite nanoparticles: Efficient photocatalyst for photodegradation of textile dye. Mater. Today: Proc. 2019, 14, 453–460. [Google Scholar] [CrossRef]
- Bhosale, S.V.; Ekamble, P.S.; Bhoraskar, S.V.; Mathe, V.L. Effect of surface properties of NiFe2O4 nanoparticles synthesized by dc thermal plasma route on antimicrobial activity. Appl. Surf. Sci. 2018, 441, 724–733. [Google Scholar] [CrossRef]
- Ashour, A.H.; El-Batal, A.I.; Abdel Maksoud, M.I.A.; El-Sayyad, G.S.; Labib, Sh.; Abdeltwab, E.; El-Okr, M.M. Antimicrobial activity of metal-substituted cobalt ferrite nanoparticles synthesized by sol-gel technique. Particuology 2018, 40, 141–151. [Google Scholar] [CrossRef]
- Taguba, M.A.M.; Ong, D.C.; Ensano, B.M.B.; Kan, C.-C.; Grisdanurak, N.; Yee, J.-J.; de Luna, M.D.G. Nonlinear isotherm and kinetic modeling of Cu(II) and Pb(II) uptake from water by MnFe2O4/Chitosan nanoadsorbents. Water 2021, 13, 1662. [Google Scholar] [CrossRef]
- Mylarappa, M.; Lakshmi, V.V.; Mahesh, K.R.V.; Nagaswarupa, H.P.; Raghavendra, N. Recovery of Mn-Zn ferrite from waste batteries and development of rGO/Mn-Zn ferrite nanocomposite for water purification. Mater. Today Proc. 2019, 9, 256–265. [Google Scholar] [CrossRef]
- Reddy, D.H.K.; Yun, Y.-S. Spinel ferrite magnetic adsorbents: Alternative future materials for water purification? Coord. Chem. Rev. 2016, 315, 90–111. [Google Scholar] [CrossRef]
- Zhang, H.; Li, C.; Lyu, L.; Hu, C. Surface oxygen vacancy inducing peroxymonosulfate activation through electron donation of pollutants over cobalt-zinc ferrite for water purification. Appl. Catal. B Environ. 2020, 270, 118874. [Google Scholar] [CrossRef]
- Masunga, N.; Mmelesi, O.K.; Kefeni, K.K.; Mamba, B.B. Recent advances in copper ferrite nanoparticles and nanocomposites synthesis, magnetic properties and application in water treatment: A review. J. Environ. Chem. Eng. 2019, 7, 103179. [Google Scholar] [CrossRef]
- Sharma, L.; Kakkar, R. Magnetically retrievable one-pot fabrication of mesoporous magnesium ferrite (MgFe2O4) for the remediation of chlorpyrifos and real pesticide wastewater. J. Environ. Chem. Eng. 2018, 6, 6891–6903. [Google Scholar] [CrossRef]
- Dobaradaran, S.; Nodehi, R.N.; Yaghmaeian, K.; Jaafari, J.; Niari, M.H.; Bharti, A.K.; Agarwal, S.; Gupta, V.K.; Azari, A.; Shariatifar, N. Catalytic decomposition of 2-chlorophenol using ultrasonic-assisted Fe3O4-TiO2@MWCNT systems: Influence factors, pathway and mechanism study. J. Colloid Interface Sci. 2018, 512, 172–189. [Google Scholar] [CrossRef] [Green Version]
- Simeonidis, K.; Mourdikoudis, S.; Kaprara, E.; Mitrakas, M.; Polavarapu, L. Inorganic engineered nanoparticles in drinking water treatment: A critical review. Environ. Sci. Water Res. Technol. 2016, 2, 43–70. [Google Scholar] [CrossRef] [Green Version]
- Bohara, R.A.; Throat, N.D.; Mulla, N.A.; Pawar, S.H. Surface-modified cobalt ferrite nanoparticles for rapid capture, detection, and removal of pathogens: A potential material for water purification. Appl. Biochem. Biotechnol. 2017, 182, 598–608. [Google Scholar] [CrossRef]
- Springer, V.; Barreiros, L.; Avena, M.; Segundo, M.A. Nickel ferrite nanoparticles for removal of polar pharmaceuticals from water samples with multi-purpose features. Adsorption 2018, 24, 431–441. [Google Scholar] [CrossRef]
- Wang, Y.; Miao, Y.; Li, G.; Su, M.; Chen, X.; Zhang, H.; Zhang, Y.; Jiao, W.; He, Y.; Yi, J.; et al. Engineering ferrite nanoparticles with enhanced magnetic response for advanced biomedical applications. Mater. Today Adv. 2020, 8, 100119. [Google Scholar] [CrossRef]
- Kefeni, K.K.; Msagati, T.A.M.; Nkambule, T.T.; Mamba, B.B. Spinel ferrite nanoparticles and nanocomposites for biomedical applications and their toxicity. Mater. Sci. Eng. C 2020, 107, 110314. [Google Scholar] [CrossRef] [PubMed]
- Thakur, P.; Chahar, D.; Taneja, S.; Bhalla, N.; Thakur, A. A review on MnZn ferrites: Synthesis, characterization and applications. Ceram. Int. 2020, 46, 15740–15763. [Google Scholar] [CrossRef] [PubMed]
- Teixeira, S.S.; Amaral, F.; Graca, M.P.F.; Costa, L.C. Comparison of lithium ferrite powders prepared by sol-gel and solid-state reaction methods. Mater. Sci. Eng. B. 2020, 255, 114529. [Google Scholar] [CrossRef]
- Zhang, L.; Wang, Y.; Liu, B.; Wang, J.; Han, G.; Zhang, Y. Characterization and property of magnetic ferrite ceramics with interesting multilayer structure prepared by solid-state reaction. Ceram. Int. 2021, 47, 10927–10939. [Google Scholar] [CrossRef]
- Harris, V.G.; Sepelak, V. Mechanochemically processed zinc ferrite nanoparticles: Evolution of structure and impact of induced cation inversion. J. Magn. Magn. Mater. 2018, 465, 603–610. [Google Scholar] [CrossRef]
- Luo, J. Nanosize Ce3+ added MgCuZn ferrite powders prepared by mechanochemical process: Synthesis, characterization and magnetic properties. Mater. Lett. 2013, 98, 174–177. [Google Scholar] [CrossRef]
- Qin, H.; He, Y.; Xu, P.; Huang, D.; Wang, Z.; Wang, H.; Wang, Z.; Zhao, Y.; Tian, Q.; Wang, C. Spinel ferrites (MFe2O4): Synthesis, improvement and catalytic application in environment and energy field. Adv. Colloid Interface Sci. 2021, 294, 102486. [Google Scholar] [CrossRef]
- Tsay, C.-Y.; Chiu, Y.-C.; Tseng, Y.-K. Investigation on structure, magnetic, and FMR properties for hydrothermally-synthesized magnesium-zinc ferrite nanoparticles. Phys. B Condens. Matter. 2019, 570, 29–34. [Google Scholar] [CrossRef]
- Shen, W.; Zhang, L.; Zhao, B.; Du, Y.; Zhou, X. Growth mechanism of octahedral-like nickel ferrite crystals prepared by modified hydrothermal method and morphology dependent magnetic performance. Ceram. Int. 2018, 44, 9809–9815. [Google Scholar] [CrossRef]
- Das, J.; Moholkar, V.S.; Chakma, S. Structural, magnetic and optical properties of sonochemically synthesized Zr-ferrite nanoparticles. Powder Technol. 2018, 328, 1–6. [Google Scholar] [CrossRef]
- Yadav, R.S.; Kuritka, I.; Vilcakova, J.; Jamatia, T.; Machovsky, M.; Skoda, D.; Urbanek, P.; Masar, M.; Urbanek, M.; Kalina, L.; et al. Impact of sonochemical synthesis condition on the structural and physical properties of MnFe2O4 spinel ferrite nanoparticles. Ultrason. Sonochemistry 2020, 61, 104839. [Google Scholar] [CrossRef]
- Berezhnaya, M.V.; Mittova, I.Ya.; Perov, N.S.; Al’myasheva, O.V.; Nguyen, A.T.; Mittova, V.O.; Bessalova, V.V.; Viryutina, E.L. Production of zinc-doped yttrium ferrite nanopowders by the sol-gel method. Russ. J. Inorg. Chem. 2018, 63, 742–746. [Google Scholar] [CrossRef]
- De-Leon-Prado, L.E.; Cortes-Hernandez, D.A.; Almanza-Robles, J.M.; Escobedo-Bocardo, J.C.; Sanchez, J.; Reyes-Rdz, P.Y.; Jasso-Teran, R.A.; Hurtado-Lopez, G.F. Synthesis and characterization of nanosized MgxMn1-xFe2O4 ferrites by both sol-gel and thermal decomposition methods. J. Magn. Magn. Mater. 2017, 427, 230–234. [Google Scholar] [CrossRef]
- Martinson, K.D.; Panteleev, I.B.; Shevchik, A.P.; Popkov, V.I. Effect of Red/Ox ratio on the structure and magnetic behavior of Li0.5Fe2.5O4 nanocrystals synthesized by solution combustion approach. Lett. Mater. 2019, 9, 475–479. [Google Scholar] [CrossRef] [Green Version]
- Popkov, V.I.; Almjasheva, O.V.; Nevedomskiy, V.N.; Panchuk, V.V.; Semenov, V.G.; Gusarov, V.V. Effect of spatial constraints on the phase evolution of YFeO3-based nanopowders under heat treatment of glycine-nitrate combustion products. Ceram. Int. 2018, 44, 20906–20912. [Google Scholar] [CrossRef]
- Amiri, M.; Salavati-Niasari, M.; Akbari, A. Magnetic nanocarriers: Evolution of spinel ferrites for medical applications. Adv. Colloid Interface Sci. 2019, 265, 29–44. [Google Scholar] [CrossRef] [PubMed]
- Martinson, K.D.; Cherepkova, I.A.; Panteleev, I.B.; Popkov, V.I. Single-step solution-combustion synthesis of magnetically soft NiFe2O4 nanopowders with controllable parameters. Int. J. Self-Propagating High-Temp. Synth. 2019, 28, 266–270. [Google Scholar] [CrossRef]
- Aruna, S.T.; Mukasyan, A.S. Combustion synthesis and nanomaterials. Curr. Opin. Solid State Mater. Sci. 2008, 12, 44–50. [Google Scholar] [CrossRef]
- Popkov, V.I.; Martinson, K.D.; Kondrashkova, I.S.; Enikeeva, M.O.; Nevedomskiy, V.N.; Panchuk, V.V.; Semenov, V.G.; Volkov, M.P.; Pleshakov, I.V. SCS-assisted production of EuFeO3 core-shell nanoparticles: Formation process, structural features and magnetic behavior. J. Alloy. Compd. 2021, 859, 157812. [Google Scholar] [CrossRef]
- Tikhanova, S.M.; Lebedev, L.A.; Martinson, K.D.; Chebanenko, M.I.; Buryanenko, I.V.; Semenov, V.G.; Nevedomskiy, V.N.; Popkov, V.I. The synthesis of novel heterojunction h-YbFeO3/o-YbFeO3 photocatalyst with enhanced Fenton-like activity under visible light. New J. Chem. 2021, 45, 1541–1550. [Google Scholar] [CrossRef]
- Martinson, K.D.; Ivanov, A.A.; Panteleev, I.B.; Popkov, V.I. Pre-ceramic nanostructured LiZnMn-ferrite powders: Synthesis, structure, and electromagnetic properties. Glas. Ceram. 2020, 77, 215–220. [Google Scholar] [CrossRef]
- Martinson, K.D.; Sakhno, D.D.; Belyak, V.E.; Kondrashkova, I.S. Ni0.4Zn0.6Fe2O4 nanopowders by solution-combustion synthesis: Influence of Red/Ox ratio on their morphology, structure and magnetic properties. Int. J. Self-Propagating High-Temp. Synth. 2020, 29, 202–207. [Google Scholar] [CrossRef]
- Kazin, A.P.; Rumyantseva, M.N.; Prusakov, V.E.; Suzdalev, I.P.; Gaskov, A.M. Cation distribution in nanocrystalline NixZn1-xFe2O4 spinel ferrites. Inorg. Mater. 2012, 48, 525–530. [Google Scholar] [CrossRef]
- Ghosh, B.; Sardar, M.; Banerjee, S. Effect of antisite formation on magnetic properties of nickel-zinc ferrite particles. J. Appl. Phys. 2013, 114, 183903. [Google Scholar] [CrossRef]
- El-Sayed, A.M. Influence of zinc content on some properties of Ni-Zn ferrites. Ceram. Int. 2002, 28, 363–367. [Google Scholar] [CrossRef]
- Srinivas, Ch.; Tirupanyam, B.V.; Meena, S.S.; Yusuf, S.M.; Babu, Ch.S.; Ramakrishna, K.S.; Potukuchi, D.M.; Sastry, D.L. Structural and magnetic characterization of co-precipitated NixZn1-xFe2O4 ferrite nanoparticles. J. Magn. Magn. Mater. 2016, 407, 135–141. [Google Scholar] [CrossRef]
- Varma, A.; Mukasyan, A.S.; Rogachev, A.S.; Manukyan, K.V. Solution combustion synthesis of nanoscale materials. Chem. Rev. 2016, 116, 14493–14586. [Google Scholar] [CrossRef]
- Martinson, K.D.; Cherepkova, I.A.; Sokolov, V.V. Formation of cobalt ferrite nanoparticles during the burning of glycine-nitrate and their magnetic properties. Glas. Phys. Chem. 2018, 44, 21–25. [Google Scholar] [CrossRef]
- Zawadzka, K.; Kadziota, K.; Felczak, A.; Wronska, N.; Piwonska, I.; Kisielewska, A.; Lisowska, K. Surface area or diameter—which factor really determines the antibacterial activity of silver nanoparticles grown on TiO2 coatings? New J. Chem. 2014, 38, 3275–3281. [Google Scholar] [CrossRef] [Green Version]
- Yamamoto, O. Influence of particle size on the antibacterial activity of zinc oxide. Int. J. Inorg. Mater. 2001, 3, 643–646. [Google Scholar] [CrossRef]
- Bedel, N.S.; Tezcan, M.; Ceylan, O.; Gurdag, G.; Cicek, H. Effects of pore morphology and size on antimicrobial activity of chitosan/poly(ethylene glycol) diacrylate macromer semi-IPN hydrogels. J. Appl. Polym. Sci. 2015, 132, 42707. [Google Scholar] [CrossRef]
- Allgayer, R.; Yousefi, N.; Tufenkji, N. Graphene oxide sponge as adsorbent for organic contaminants: Comparison with granular activated carbon and influence of water chemistry. Environ. Sci. Nano. 2020, 7, 2669–2680. [Google Scholar] [CrossRef]
- Massoudi, J.; Smari, M.; Khirouni, K.; Dhahri, E.; Bessais, L. Impact of particle size on the structural and magnetic properties of superparamagnetic Li-ferrite nanoparticles. J. Magn. Magn. Mater. 2021, 528, 167806. [Google Scholar] [CrossRef]
- Peddis, D.; Cannas, C.; Musini, A.; Ardu, A.; Orru, F.; Fiorani, D.; Laureti, S.; Rinaldi, D.; Muscas, G.; Concas, G.; et al. Beyond the effect of particle size: Influence of CoFe2O4 nanoparticle arrangements on magnetic properties. Chem. Mater. 2013, 25, 2005–2013. [Google Scholar] [CrossRef]
- Ishaq, K.; Saka, A.A.; Kamardeen, A.O.; Ahmed, A.; Alhassan, M.I.; Abdullahi, H. Characterization and antibacterial activity of nickel doped a-alumina nanoparticles. Eng. Sci. Technol. Int. J. 2017, 20, 563–569. [Google Scholar] [CrossRef]
- Maksoud, M.I.A.A.; El-Sayyad, G.S.; Abokhadra, A.; Soliman, L.I.; El-Bahnasawy, H.H.; Ashour, A.H. Influence of Mg2+ substitution on structural, optical, magnetic, and antimicrobial properties of Mn-Zn ferrite nanoparticles. J. Mater. Sci. Mater. Electron. 2020, 31, 2598–2616. [Google Scholar] [CrossRef]
- Gheidari, D.; Mehrdad, M.; Maleki, S.; Samanesadat, H. Synthesis and potent antimicrobial activity of CoFe2O4 nanoparticles under visible light. Heliyon 2020, 6, 05058. [Google Scholar] [CrossRef]
- Martinson, K.D.; Beliaeva, A.D.; Nianikova, G.G.; Panteleev, I.B. SCS-assisted preparation of magnetically soft Li and LiZnMn ferrite nanopowders with enhanced bioavailability and bioactivity suitable for use in food technology. IOP Conf. Ser. Earth Environ. Sci. 2021, 723, 032107. [Google Scholar] [CrossRef]

| Sample | D111, nm | Dmax, nm | ρxrd, cm3/g | α, Å | V, Å3 | Rwp, % |
|---|---|---|---|---|---|---|
| ZnFe2O4 | 41.4 | 36.62 | 5.38 | 8.421 (4) | 597.245 (5) | 1.98 |
| Ni0.3Zn0.7Fe2O4 | 37.5 | 32.85 | 5.39 | 8.394 (7) | 591.582 (8) | 2.15 |
| Ni0.7Zn0.3Fe2O4 | 35.1 | 30.43 | 5.35 | 8.344 (2) | 580.970 (5) | 2.17 |
| NiFe2O4 | 35.7 | 29.54 | 5.34 | 8.332 (5) | 576.449 (6) | 2.24 |
| Sample | At % | ||
|---|---|---|---|
| Zn | Ni | Fe | |
| ZnFe2O4 | 32.92 | - | 67.08 |
| Ni0.3Zn0.7Fe2O4 | 9.95 | 23.25 | 66.80 |
| Ni0.7Zn0.3Fe2O4 | 23.28 | 9.97 | 66.75 |
| NiFe2O4 | - | 33.4 | 66.6 |
| Test Culture | Ferrite | Concertation, mg/ml | Inhibition Zone Diameter, mm | Ref |
|---|---|---|---|---|
| B. cereus | CoFe2O4 | 48 | 20 | [65] |
| 24 | 16 | |||
| 12 | 14 | |||
| 6 | 12 | |||
| B. cereus | ZnFe2O4 | 20 | 13 | Current study |
| Ni0.3Zn0.7Fe2O4 | 20 | 15 | ||
| Ni0.7Zn0.3Fe2O4 | 20 | 16 | ||
| NiFe2O4 | 20 | 18 | ||
| E. coli | NiFe2O4 | 75 | 11 | [18] |
| 100 | 15 | |||
| 125 | 17 | |||
| 150 | 19 | |||
| E. coli | ZnFe2O4 | 20 | 14 | Current study |
| Ni0.3Zn0.7Fe2O4 | 20 | 15 | ||
| Ni0.7Zn0.3Fe2O4 | 20 | 15 | ||
| NiFe2O4 | 20 | 17 | ||
| S. citreus | Mn0.5Zn0.5Fe2O4 | 20 | 10 | [66] |
| S. citreus | ZnFe2O4 | 20 | 21 | This work |
| Ni0.3Zn0.7Fe2O4 | 20 | 20 | ||
| Ni0.7Zn0.3Fe2O4 | 20 | 23 | ||
| NiFe2O4 | 20 | 26 | ||
| C. tropicalis | Mn0.5Zn0.5Fe2O4 | 20 | 10 | [66] |
| Mn0.5Zn0.375Mg0.125Fe2O4 | 20 | 10 | ||
| Mn0.5Zn0.125Mg0.375Fe2O4 | 20 | 11 | ||
| Mn0.5Mg0.5Fe2O4 | 20 | 14 | ||
| C. tropicalis | ZnFe2O4 | 20 | 18 | Current study |
| Ni0.3Zn0.7Fe2O4 | 20 | 17 | ||
| Ni0.7Zn0.3Fe2O4 | 20 | 24 | ||
| NiFe2O4 | 20 | 27 |
| Test-Culture | Concentration of Ferrite, mg/mL | |||
|---|---|---|---|---|
| ZnFe2O4 | Ni0.3Zn0.7Fe2O4 | Ni0.7Zn0.3Fe2O4 | NiFe2O4 | |
| Bacillus cereus | 12.5 | 6.25 | 3.125 | 3.125 |
| Escherichia coli | 12.5 | 6.25 | 3.125 | 3.125 |
| Staphylococcus citreus | 25.0 | 12.5 | 6.25 | 3.125 |
| Candida tropicalis | 12.5 | 6.25 | 3.125 | 3.125 |
Publisher’s Note: MDPI stays neutral with regard to jurisdictional claims in published maps and institutional affiliations. |
© 2022 by the authors. Licensee MDPI, Basel, Switzerland. This article is an open access article distributed under the terms and conditions of the Creative Commons Attribution (CC BY) license (https://creativecommons.org/licenses/by/4.0/).
Share and Cite
Martinson, K.D.; Beliaeva, A.D.; Sakhno, D.D.; Beliaeva, I.D.; Belyak, V.E.; Nianikova, G.G.; Panteleev, I.B.; Naraev, V.N.; Popkov, V.I. Synthesis, Structure, and Antimicrobial Performance of NixZn1−xFe2O4 (x = 0, 0.3, 0.7, 1.0) Magnetic Powders toward E. coli, B. cereus, S. citreus, and C. tropicalis. Water 2022, 14, 454. https://doi.org/10.3390/w14030454
Martinson KD, Beliaeva AD, Sakhno DD, Beliaeva ID, Belyak VE, Nianikova GG, Panteleev IB, Naraev VN, Popkov VI. Synthesis, Structure, and Antimicrobial Performance of NixZn1−xFe2O4 (x = 0, 0.3, 0.7, 1.0) Magnetic Powders toward E. coli, B. cereus, S. citreus, and C. tropicalis. Water. 2022; 14(3):454. https://doi.org/10.3390/w14030454
Chicago/Turabian StyleMartinson, Kirill D., Anna D. Beliaeva, Daria D. Sakhno, Irina D. Beliaeva, Vladislav E. Belyak, Galina G. Nianikova, Igor B. Panteleev, Vyacheslav N. Naraev, and Vadim I. Popkov. 2022. "Synthesis, Structure, and Antimicrobial Performance of NixZn1−xFe2O4 (x = 0, 0.3, 0.7, 1.0) Magnetic Powders toward E. coli, B. cereus, S. citreus, and C. tropicalis" Water 14, no. 3: 454. https://doi.org/10.3390/w14030454
APA StyleMartinson, K. D., Beliaeva, A. D., Sakhno, D. D., Beliaeva, I. D., Belyak, V. E., Nianikova, G. G., Panteleev, I. B., Naraev, V. N., & Popkov, V. I. (2022). Synthesis, Structure, and Antimicrobial Performance of NixZn1−xFe2O4 (x = 0, 0.3, 0.7, 1.0) Magnetic Powders toward E. coli, B. cereus, S. citreus, and C. tropicalis. Water, 14(3), 454. https://doi.org/10.3390/w14030454

